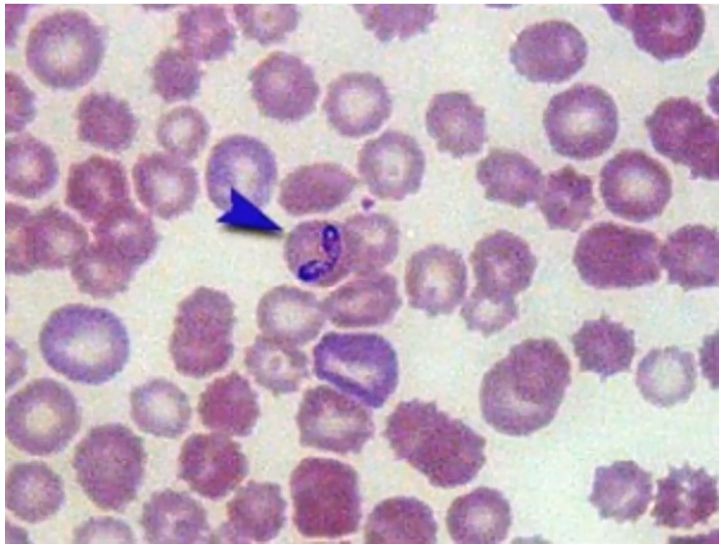
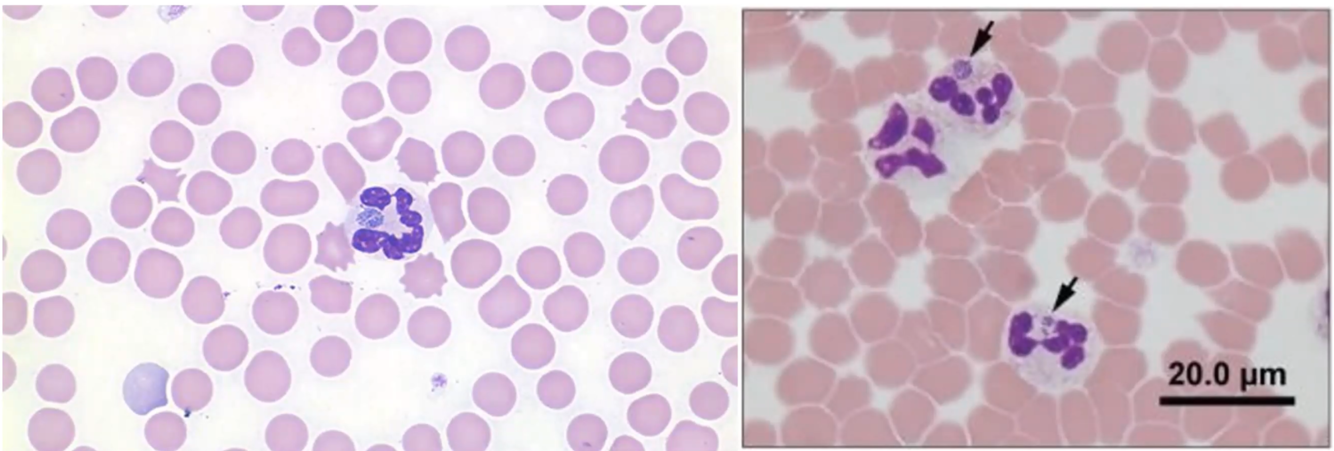
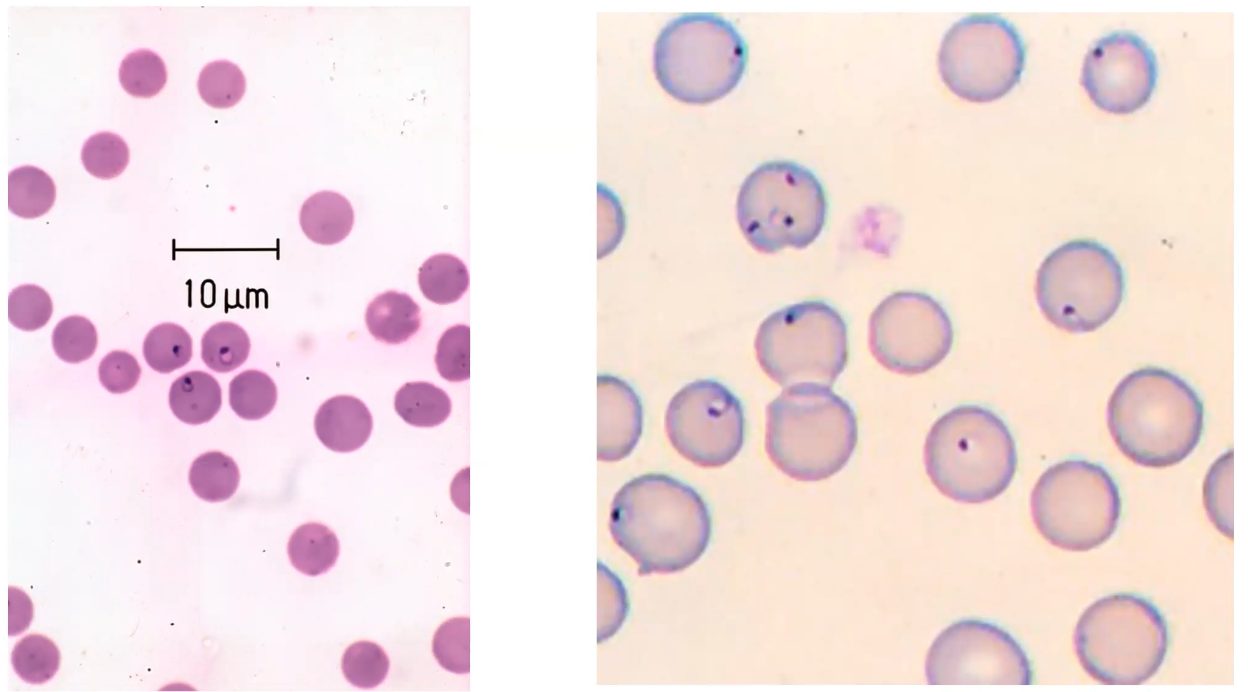

Which tick is most commonly responsible for Borrelia burgdorferi in the USA and, conversely, Europe?
USA: Ixodes scapularis, I. pacificus in the pacific states.
Europe: Ixodes ricinus
What other bacterial organism is co-transmitted with B. burgdorferi?
Anaplasma phagocytophilum.
Which is the more common manifestation of Lyme disease in dogs: Lyme nephritis or arthritis?
Arthritis
Which European breed is more often reported to be seropositive to Lyme disease?
Bernese mountain dog.
Which Borrelia antigens are not present in vaccines?
C6, VlsE and OspF
n.b. OspA, in contrast, is more in vaccinated
Which serological tests are not recommended for diagnosis of Borrelia?
Whole cell ELISA
IFA
Western blot
IgM vs. IgG.
How long should Borrelia be treated for (clinically affected cases)?
4 weeks
What treatment is recommended for immune complex glomerulonephritis?
Mycophenolate - minimum of 12 weeks as an immunosuppressive ‘trial’
Prednisolone can be considered for extremely financially constrained cases.
What is the recommended screening for dogs living in Borrelia endemic areas in North America?
Annual qualitative antibody assays. If seropositive then perform follow up proteinuria screening (2-3x yearly) and minimum database.
What surface protein do Borrelia vaccines act against?
OspA - thus preventing transmission from the tick to the dog. Some also do OspC.
What is the organism in the picture?
Babesia, a big one!
What is the organism in the atached picture?

Mycoplasma
What is the organism in the attached picture?
Anaplasma (note that these are morula inside a granulocyte)
What is the organism in the attached picture?

Ehrlichia - note that the morula is within a monocyte (in contrast to Anaplasma that would be in a granulocyte like a neutrophil).
What is the organism in the attached picture?
Cytauxzoan
What is the organism in the attached picture?

Borrelia (Lyme disease)
Which organisms may be present within the following vector?

Babesia
Ehrlichia canis
Bartonella vinsonii ss. berkhoffi
Hepatozoon canis
Which organisms may be present within the following vector?

Ehrlicia chaffenesis
Ehrlichia ewingii
Cytauxzoonosis
Hepatozoon americanum
Which organisms may be present within the following vector?

Babesia
Anaplasma phagocytophilium
Borrelia
Which organisms may be present within the following vector?

Babesia
Rocky mountain spotted fever
Cytauxzoonosis
Identify the organisms and vectors

Top - B. canis
Bottom - B. gibsoni
Vector = Rhipicephalus sanguniaeus, Dermacentor and Ixodes
Which breed seems predisposed to Babesia canis vogeli?
Greyhounds
Which breed would you be most concerned about B. gibsoni?
Pitbulls - this seems typically to be transmitted by fighting dogs although some tick transmission can occur,
Outline the lifecycle of B. canis
